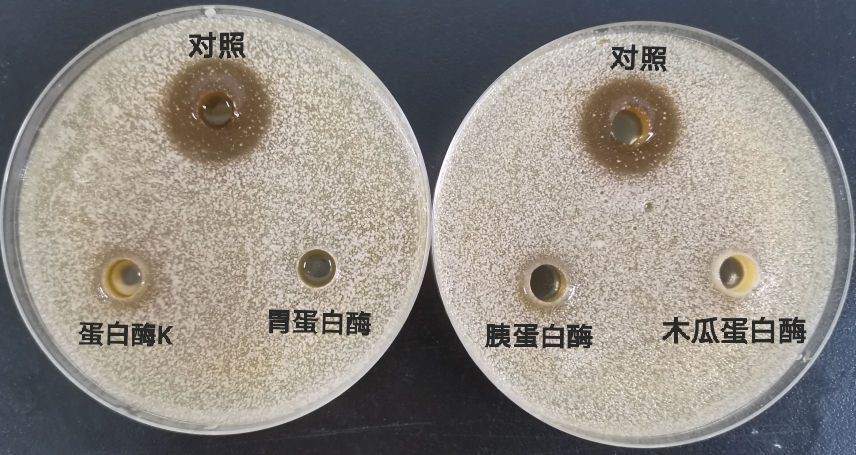

中国泡菜以四川泡菜为代表,因四川泡菜的独特风味和口感,使其成为了川菜的重要原料和调味料。泡菜原料自带微生物群落组成直接影响泡菜产品质量。为了对泡菜品质质量进行正向调控,川渝共建特色食品重庆市重点实验室成员,博牛社区
索化夷教授和张玉副教授课题组在泡菜品质控制方面取得了系列研究进展,相关成果发表在Food Chemistry、Food Science & Nutrition等国际期刊。


图1.泡菜的理化特性(pH、总酸、21 种游离氨基酸、8种有机酸、4种质地特性)和优势细菌(A)和真菌(B)物种之间的 Spearman相关性热图
这项研究利用高通量测序技术对泡菜的微生物结构进行了分析,并与泡菜品质相关的理化属性为基础确定了关键微生物群落。结果表明,在发酵过程中,细菌多样性水平显著降低,而真菌多样性在不同的α-多样性指数之间不一致。厚壁菌和变形菌是所有样本中的主要菌门。乳酸菌,是属和种水平上的优势菌。真菌与理化属性之的相关性较弱,植物乳杆菌、耐乙酰乳杆菌和西氏魏氏菌等细菌物种与理化属性显著相关。总的来说,该研究确定了泡菜关键微生物群落,并讨论了它们的功能作用,有助于持续生产高品质的泡菜。


图2 发酵乳杆菌SHY10对产膜酵母菌的抑制作用
(注:a:无菌上清液;b:有外包物的菌体;c:无外包物的菌体)
图3 蛋白酶对乳杆菌SHY10无菌上清液的影响
结果表明,发酵乳杆菌SHY10能够抑制泡菜“生花”主要是无菌上清液的作用(图2)。不同蛋白酶处理的发酵乳杆菌SHY10无菌上清液,无菌上清液对产膜菌无抑制作用或抑制作用明显减弱(图3),表明无菌上清液抑制产膜菌的活性成分为蛋白类物质。该研究不仅表明了乳杆菌SHY10无菌上清液作为抑菌剂应用于泡菜“生花”现象具有广阔的前景,也为研究泡菜的产膜抑制作用机制提供了理论支撑。
(张玉 供稿;孙康 审稿;曾亮、吴俊平审稿)